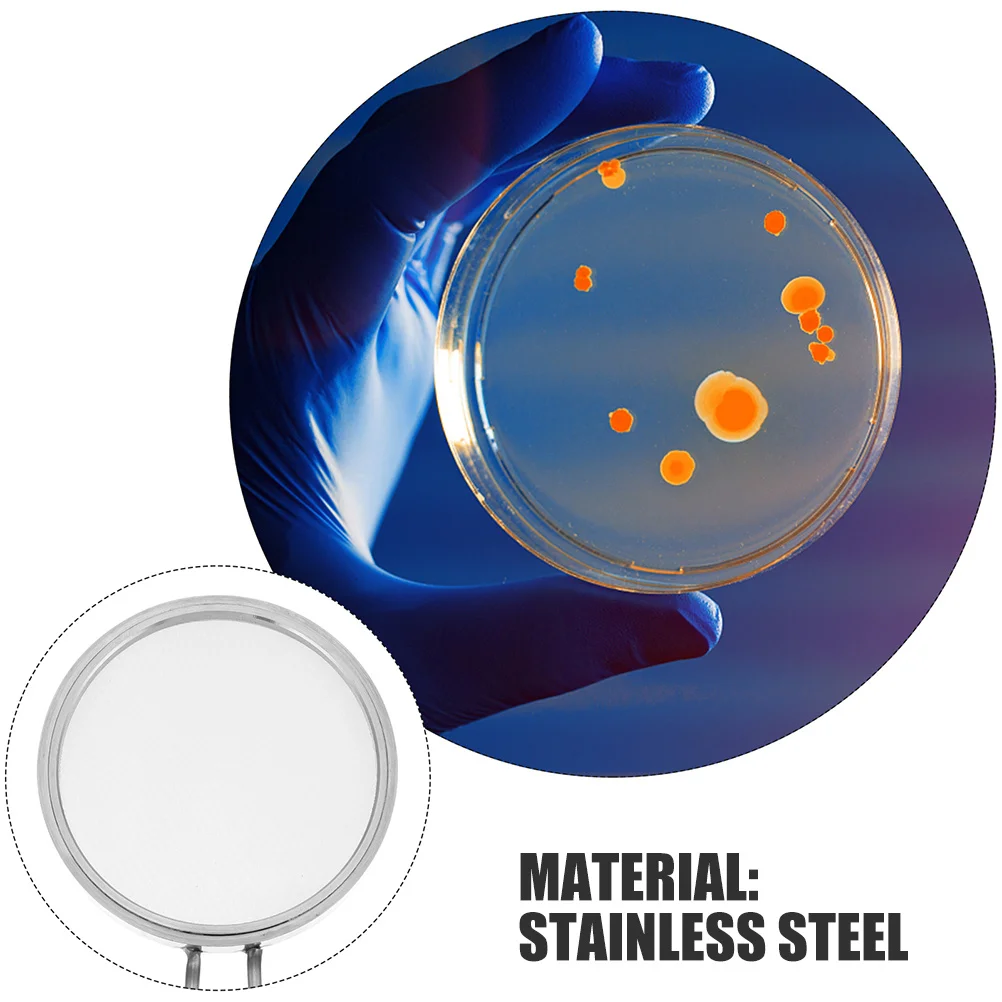

Новая Оригинальная Военная серия MOC Kar 98K снайперская винтовка, строительный блок, пистолет, модель может стрелять, собранные кирпичные игру...














артикул: 1005004071647756
СОГЛАСНО НАШИМ ДАННЫМ, ЭТОТ ПРОДУКТ СЕЙЧАС НЕ ДОСТУПЕН
$110.14
Доставка из: Китай
График изменения цены & курс обмена валют
Пользователи также просматривали

$206.69
Ультрабук Б-класс Dell Latitude E5470 / 14" (1366x768) TN / Intel Core i5-6440HQ (4 ядра по 2.6 - 3.5 GHz) / 16 GB DDR4 / 256 GB SSD / Intel HD Graphics 530 / WebCam / SIM / HDMI
compbest.com.ua
$10.93
For Volkswagen VW Bora Jetta Vento MK4 MK5 MK6 MK7 Car Window Sunshade Cover Sun Shade Windshield Visor Protector Windscreen
aliexpress.ru
$330.00
A11VO Pump Rotary Group Kits Hydraulic Pump Accessories for Rexroth A11VO40 Axial Piston Pump Spare Parts Repair Kits
aliexpress.ru
$7.09
Hot Selling Men Boots Outdoor High Top Sneakers Lace Up Anti Slip Male Shoes Comfort Durable Tooling Boots Zapatillas De Deporte
aliexpress.ru
$57.42
Brake and Clutch Lever Protector Kit For YAMAHA MT07 MT-07 FZ-07 YAMAH XSR700 Motorcycle Handlebar Brake Clutch Lever Protective
aliexpress.com
$7.99
Men Women MAMA Letter Embroidery Baseball Caps Cotton Adjustable Snapback hats Hip Hop mesh Cap summer Outdoor Sun hat Dad Hats
aliexpress.com
$19.64
Chunky Women Casual Shoes Women Fashion Summer Sequin Canvas Sneakers Women Shallow Platform Vulcanize Shoes Zapatillas Mujer
aliexpress.com
$7.81
9.6V Rechargeable Battery For Rc toys Car Tanks Trains Robot Boat Gun tools AA Ni-Cd 9.6v 3000mAh Battery For Emergency Lamp
aliexpress.com
$7.51
Summer Fashion Skull Cotton Men's T-shirt Men Short Sleeve Printed T Shirt Top Tshirt Clothing Free Shipping
aliexpress.com
$12.40
Противоскользящий коврик для ванной, сауны, бассейна JOYARTY, Разноцветный (мультиколор), Учимся считать
vseinstrumenti.ru
$10.07
Новинка, умные часы, спортивный трекер артериального давления, Водонепроницаемый Bluetooth Смарт-браслет, мониторинг пульса для Android Ios
aliexpress.ru
$61.98
Для BMW X1 X2 X3 X4 X5 X6 X7 F15 Автомобильный подголовник поддержка шеи сиденья подушка для шеи наппа кожаная вышивка автомобильные аксессуары
aliexpress.ru
$650.00
Лето 2022, скидка 50%, распродажа, купите 5 и получите 3 бесплатных мини-комплекта Garmin Alpha 100/TT 15
aliexpress.ru
$6.40
5piece of Minimalist Landscape Poster Canvas Wall Art Mural Frameless Modern Turquoise Living Room Home Decoration Painting
aliexpress.com
$299.21
Шкаф купе Luxe Studio Стандарт-1 ДСП/Тонированное зеркало 1800x2300x450 двухдверный
rozetka.com.ua
$3.69
!ACCEZZ Metal Bass Stereo Surround 3.5mm Earphones Wire Control In-Ear Sport Earbuds For iPhone Samsung MP3 Headsets With HD Mic
aliexpress.com
$5.99
Real Leather Flip Tablet Case For Apple iPad 2/3/4 Auto Sleep Smart Kickstand Cover iPad2 ipad3 ipad4 9.7 inch Coque Fundas Euti
aliexpress.com
$5.79
Canvas Printing Hanging Storage Bag 4/5 Pockets Wall Mounted Wardrobe Hang Bag Wall Pouch Cosmetic Toys Organizer
aliexpress.com
$18.86
1Set Multifunction Camping Cookware Portable Stainless Steel Outdoor Cooking Pot Pan Set Lightweight Camping Supplies
aliexpress.ru
$6.32
2pcs Heavy Duty Stainless Steel Spring Loaded Universal Carriage Door For Carriage Lock Spring Latch Replacement
aliexpress.ru
$7.05
Horse Lovers Design Dirt, Horse Smells And Dog Slobber Apron Chef Uniform For Men Cooking work ladies kitchen jacket woman Apron
aliexpress.ru
$15.60
Трубка подачи масла турбонаддува для Buick Encore Chevrolet Cruze 1.4 Opel Vauxhall 55592600 Автомобильные аксессуары
aliexpress.ru
$18.77
Nightclub Sexy Men Cosplay Men Lingerie Sexy Doctor Male Nurse Sexy Uniform Seduction
aliexpress.ru
$330.64
AL barber shop chair Internet celebrity hair salon salon salon chair lift reclining perm seat stool
aliexpress.ru
$5.19
Фотохромные мультифокальные очки для чтения в большой оправе в стиле ретро с защитой от синего света, очки для пресбиопии, меняющие цвет, очки для дальнего видения
aliexpress.ru
$5.22
Отвертка для зубного имплантата 1 шт. — динамометрический ключ (10-70 НМ) для универсального имплантического восстановления и затяжки амортизатора
aliexpress.ru